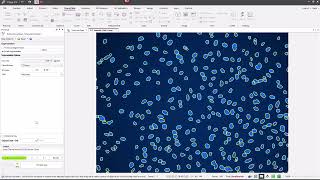

Image Pro v11: Cell Biology Protocols Live Dead video
Online izle ve mp4 mp3 formatlarinda yukle
Videonun muddeti: 6:19
Image Pro v11: Cell Biology Protocols Live Dead videosu mp4 ve mp3 yuklemek ucun hazirdir
Diqqet! Siz Mp4 yukle ve ya Mp3 yukle duymesine basdiqdan sonra eger sistem sizi reklam sehifesine atarsa o zaman derhal geri qayidib emeliyyati tekrar edin ve faylin yuklemek ucun hazir olmasini gozleyin
Videodan Mp4 Yukle
Videodan Mp3 Yukle-1
Videodan Mp3 Yukle-2
Oxshar Axtarishlar
Image-Pro v11: Cell Biology Protocols - Live Dead
Image-Pro v11: Cell Biology Plus Protocols - Angiogenesis
Image-Pro v11: Cell Biology Plus Protocols - Wound Healing
Image-Pro v11: Cell Biology Plus Protocols - Translocation (Total Cellular Area)
Image-Pro v11: Cell Biology Protocols - Lipid Droplets
Image-Pro v11: Cell Biology Protocols - Transfection (2 Labels)
Image-Pro v11: Cell Biology Protocols - Transfection (1 Label)
Image-Pro v11: Cell Biology Protocols - Apoptosis
Image-Pro v11: Cell Biology Plus Protocols - Neurite Outgrowth
Video Mp4 Mp3Azwap.Biz
Azwap.Biz 2021-2023